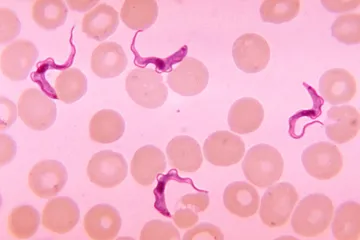
Nový lék na spavou nemoc je přelom. V rozhovoru pro ČT vysvětluje jeho autorka, jak vznikl

Předseda KSČM Vojtěch Filip vysvětloval na jednání stranického vedení dopisy finančnímu úřadu, ve kterých kritizoval kontroly ve firmě trestně stíhaného podnikatele Tomáše Horáčka. Podle místopředsedy strany Stanislava Grospiče se komunistické špičky spokojily s Filipovým názorem, že jako poslanec má právo finanční úřad interpelovat podobně, jako interpeluje ministry.
Vojtěch Filip nakonec hovořil s výkonným výborem své strany o dopisech finančnímu úřadu kvůli stíhanému podnikateli Horáčkovi jen stručně. Stanislav Grospič upřesnil, že šéf KSČM mluvil o tom, že má právo finanční úřad interpelovat. Podobně se Filip vyjádřil již dříve veřejně. „Je právem každého poslance, tedy i moje, interpelovat vedoucí správních úřadů, ne jen ministry,“ řekl.
Podle Grospiče se s tím členové výboru spokojili a nikdo nechtěl o Filipově kauze hovořit podrobněji. Neprobírali ji tedy jako speciální bod. „Ten bod nikdo nenavrhl. Bereme to tak, že se výkonný výbor s informací spokojil,“ uvedl Stanislav Grospič. Sám je přesvědčen, že jako poslanec Filip „má právo dotazovat se na cokoliv, co usoudí z hlediska okruhu činovníků veřejné správy nebo jiných osob“.
Názory komunistů na postup předsedy strany jsou ale rozpolcené. Výbor dostal dopis od skupiny členů, který je vůči Vojtěchu Filipovi velmi kritický. Signatáři žádali o co nejpodrobnější vysvětlení kauzy.
Další ale hovoří o politickém boji a snaze poškodit KSČM před nadcházejícími volbami do Evropského parlamentu. Výzvu členů odmítl předseda komunistického poslaneckého klubu Pavel Kováčik s tím, že jde o skupinu, která je vůči Filipovi kritická dlouhodobě. „Je to neustále jedna a ta samá věc a jedna a ta samá skupina lidí. Pro mě je to velmi menšinový názor určité frakce v KSČM,“ řekl.
Deník Právo napsal, že nynější předseda KSČM napsal finančnímu úřadu Ústeckého kraje dopisy, ve kterých kritizoval kontroly provedené v Horáčkově společnosti První chráněná dílna. Z kontrol vzešlo podezření na možné zneužívání evropských dotací. Filip v dopisu podle Práva varoval před propuštěním handicapovaných zaměstnanců chráněné dílny a psal o možném „šikanózním jednání“ finančního úřadu.
Tomáš Horáček je obviněn v kauze kolem nemocničních zakázek. Figurují v ní i někteří bývalí ředitelé velkých nemocnic. Horáček podle policie ovlivňoval přidělování zakázek v pražských nemocnicích, za což podle vyšetřovatelů žádal úplatky. Jeho firmy, zejména První chráněná dílna, získávaly nemocniční zakázky cíleně jako jediný uchazeč. Zdravotnická zařízení uzavřela s jeho firmou za poslední dva roky smlouvy za více než 236 milionů korun.